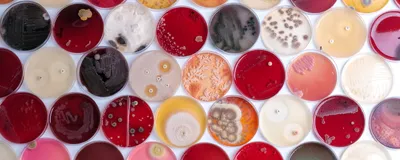
Rows of colorful petri dishes show different microorganisms, including bacteria and fungi, growing on various nutrient media.

Despite their size, microorganisms loomed large this year. Whether they helped scientists better understand the role of the gut microbiome in pregnancy and offspring development or provided new insights into traditional yogurt production practices, microbes had a big year. Check out the best microbiology stories from 2025.
Gut Bacteria Boost Levels of Sex Hormones with the Help of Flatulence
Gut microbes affect their hosts in a variety of ways, from helping digest food to influencing mood. Now, researchers at Harvard Medical School have added another job to the list: converting steroids into the sex hormone progestin. They cultured bacteria from human feces—a proxy for the gut microbiome—with glucocorticoids from bile and found that progestins appeared. They narrowed down the hormone-producing bacteria to various species in combination with Escherichia coli Nissle 1917 (EcN). EcN, it turned out, provided hydrogen gas (a common component of farts) that the other bacteria needed to convert steroids into progestin. The team also found that during pregnancy the gut microbiome produces higher levels of progestins, and they are planning to explore this connection between pregnancy and the gut microbiome further.

Flies can be a nuisance at a picnic, but can them landing on your food actually make you sick?
© iStock.com, Dhoxax
What Happens When a Fly Lands on Your Food?
No one likes it when a fly lands on their food, but can these insects actually add enough bacteria to your snack to make you sick? Researchers have mulled over this question for years. First, they investigated how much bacteria flies actually transmit to food. In one study, researchers found that when they allowed houseflies to land on milk, steak, or potato salad contaminated with E. coli, about half of the flies picked up more than 50 viable bacterial cells. While theoretically, just one bacterial cell can make people sick, whether people actually get sick depends on the kind of bacteria present. For example, people need to eat between 25 and 1,000 colony forming units (CFU) of traveler’s diarrhea-causing E. coli to get sick, whereas just two or nine CFU of Shiga-toxin producing E. coli will do the trick.

Using a traditional recipe from Romanian and Turkish practices, researchers placed four live ants into a jar of warm milk to create ant yogurt.
David Zilber
Ants Can Ferment Milk to Make Yogurt. But How?
While people most often think of yogurt being made with microbial cultures, many traditional practices add other components including green chilis, nettles, and—in Bulgaria and Turkey—ants. A team of scientists at the Technical University of Denmark recently pinpointed the bacteria, acids, and enzymes associated with adult ants and their larvae help ferment milk into yogurt. The team learned the traditional practice from community members and then characterized the microbiome of the ant species used in the process. At the end of their study, the team collaborated with Michelin star chefs to create food made with ant-based yogurt, including a mascarpone-like cheese and an ice cream sandwich that they called an “ant-wich.”
How the Mom's Microbiome Shapes a Baby's Long-Term Health
A mother’s health directly affects her developing baby, and in a study in mice, it appears that the gut microbiome plays a vital role. Scientists at the Chinese Academy of Sciences wondered if the maternal gut microbiome could affect the offspring’s stem cell function. The team added the probiotic bacterium Akkermansia muciniphila, to the diet of pregnant mice and found that pups born to mothers who received the probiotic had increased neurogenesis and more intestinal stem cells than pups born to control mice. These effects even persisted into mouse middle age. While there is some circumstantial evidence that the maternal gut microbiome-offspring axis exists in humans too, mouse studies like this one can provide more insight into potential human applications.
A Gut Pathogen’s Unexpected Weapon Against Amyloid Diseases

A protein from the stomach ulcer-causing bacterium H. pylori inhibited the formation of amyloids, which have been implicated in many neurodegenerative diseases.
© iStock.com, iLexx
Known for causing stomach ulcers, the bacterium Helicobacter pylori may one day help scientists do some good in treating human diseases. When H. pylori attacks nearby cells, it injects them with the protein cytotoxin-associated gene A protein (CagAN). Researchers at the Karolinska Institute found that CagAN can inhibit the formation of amyloid protein states, which are fibrous aggregated structures. The team showed that CagAN blocked amyloid formation in proteins of numerous sizes and changes, including amyloids made by bacteria and those implicated in the human diseases type 2 diabetes, Parkinson’s disease, and Alzheimer’s disease. The findings suggest that CagAN could help tackle both bacterial infections and human amyloid disorders to improve public health.
Retraction of Controversial Arsenic-Life Paper Stirs Debate Among Scientists
In 2010, scientists from the NASA Astrobiology Institute shook the microbiology world with a paper published in Science reporting that they had found a microbe in California’s Mono Lake that could live on arsenic. At the time, researchers pointed out methodological flaws and issues in the researchers’ interpretation of the data. Then, in July of this year, the editors at Science decided to retract the paper, listing the reason being that the experimental results reported in the study did not support its conclusions. The reactions to the retraction were mixed. Some researchers applauded the decision saying that it is important for those new to the field to not be confused by the conclusions of the work. Others thought that the move was an editorial overreach and that scientists should judge the study’s findings, not journals. Many expressed concern that the journal retracted the paper, not due to misconduct, but to the findings potentially being wrong, which they worried could erode public trust in science.